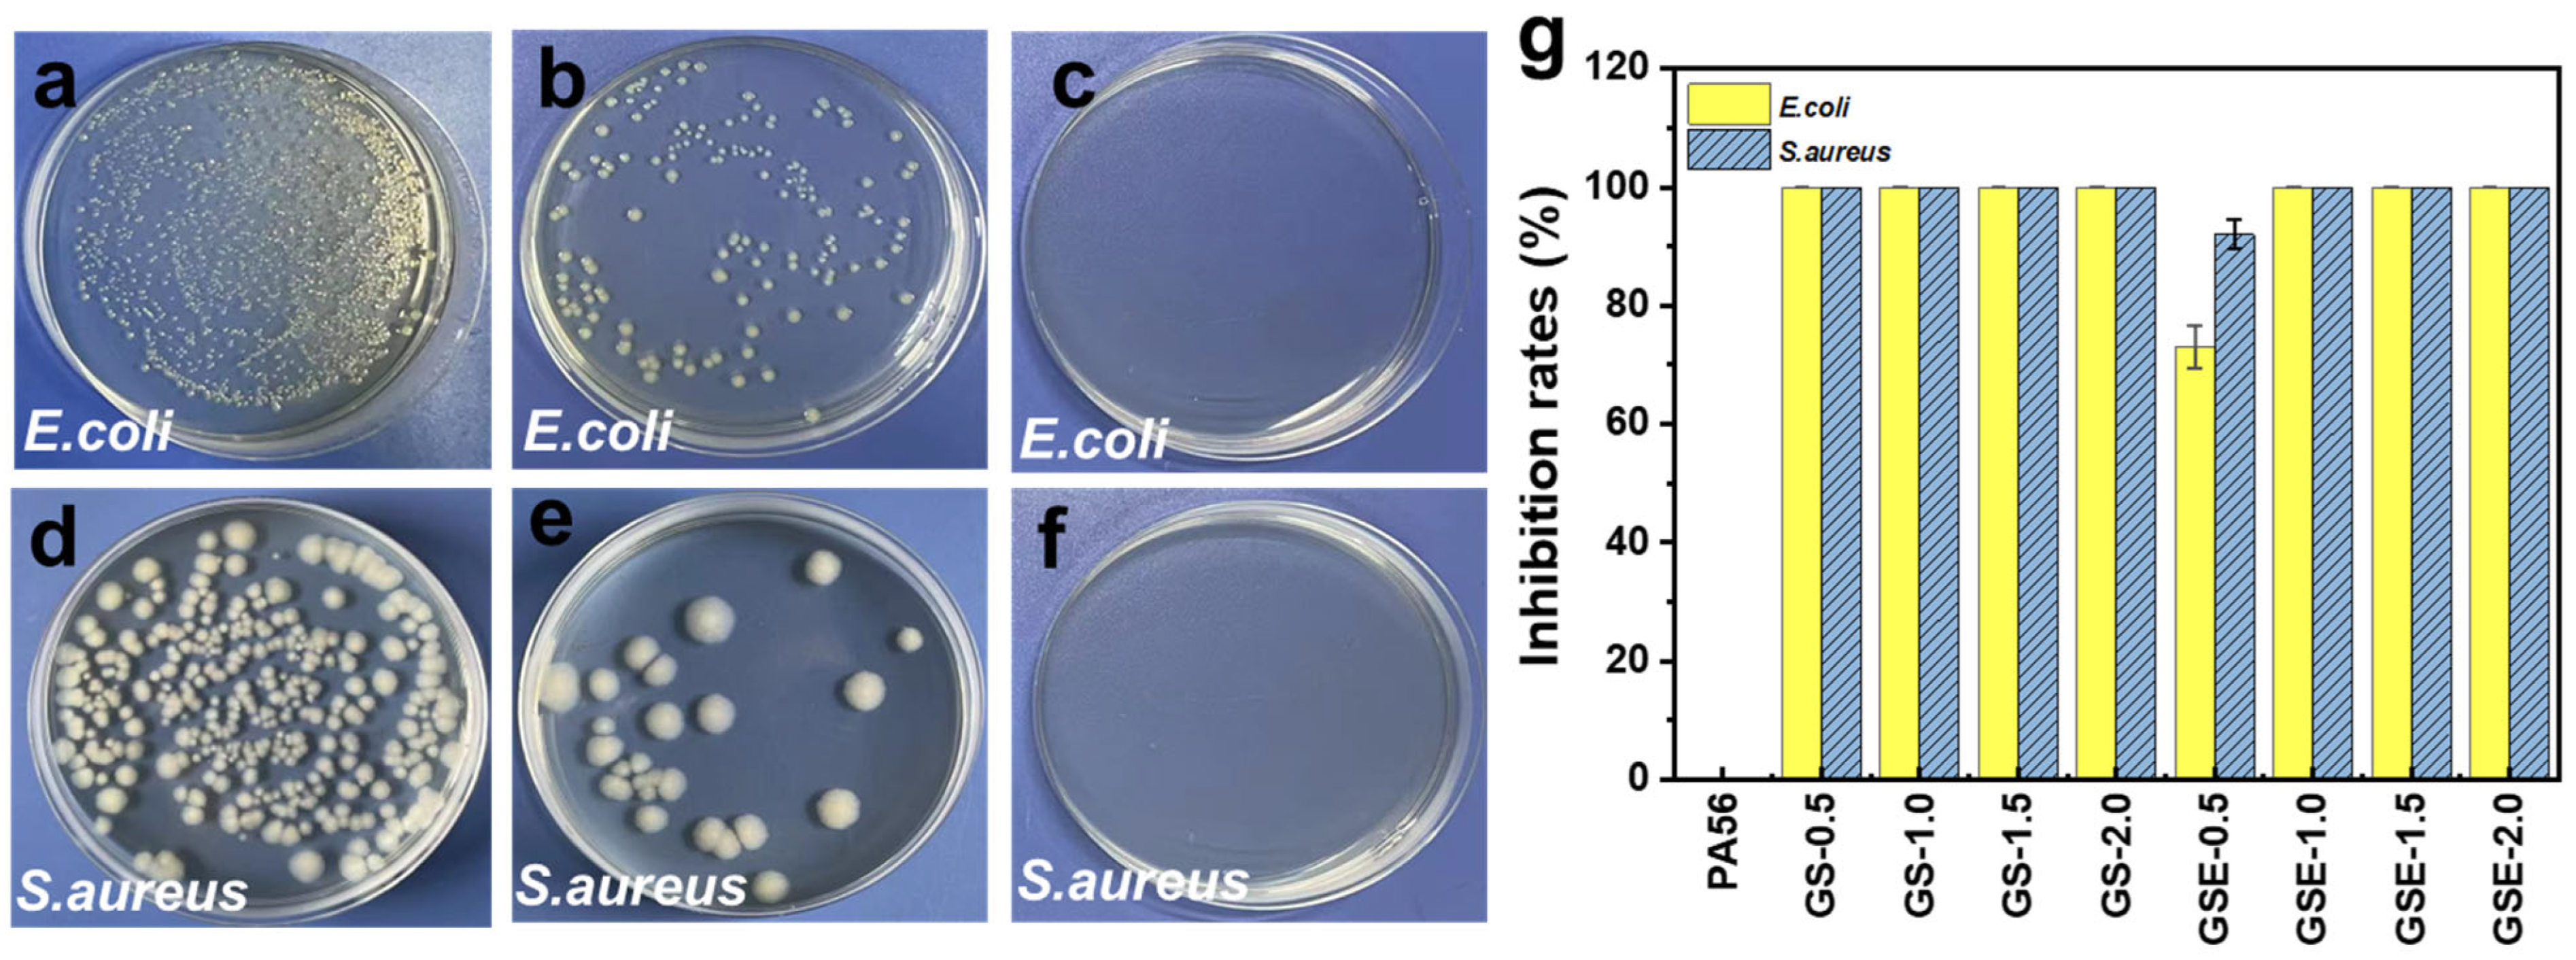
Polymers 16 02707 g009 Polymers 16 02707 g009

Guanidine Derivatives Leverage the Antibacterial Performance of Bio-Based Polyamide PA56 Fibres
Abstract
1. Introduction
2. Materials and Methods
2.1. Materials
2.2. Preparation of Functional Antibacterial PA56 Fibres
2.3. Dyeing of Stockings
2.4. Characterization
3. Results and Discussion
3.1. Sample Synthesis
3.2. Sample Morphology
3.3. Effect of PPGS on the Thermal Stability of PA56
3.4. Mechanical Properties
3.5. Colorimetric Results
3.6. Antibacterial Performance
3.7. Mechanism of PPGS and Dyes
4. Conclusions
Supplementary Materials
Author Contributions
Funding
Data Availability Statement
Acknowledgments
Conflicts of Interest
References
- Zhu, R.L.; Pu, Z.J.; Zheng, L.; Zheng, P.; Wu, F.; Yu, D.; Wang, X.; Yue, M.; Yang, Y.; Yang, K.; et al. Effect of addition of fillers (MoS2 and PFA) on the tribological and mechanical properties of biobased semi-aromatic polyamide (PA10T). Polym. Compos. 2024, 45, 3713–3723. [Google Scholar] [CrossRef]
- Wang, Y.J.; Guo, Y.T.; Zhong, S.M.; Lin, Q.S.; Gao, F.; Chen, W.; Lu, W. Oligomer composition and content in regenerated PA6 fiber and its effect on properties. J. Appl. Polym. Sci. 2024, 141, e55150. [Google Scholar] [CrossRef]
- Zheng, X.; Ding, X.; Guan, J.; Gu, Y.; Su, Z.; Zhao, Y.; Tu, Y.; Li, X.; Li, Y.; Li, J. Ionic liquid-grafted polyamide 6 by radiation-induced grafting: New strategy to prepare covalently bonded ion-containing polymers and their application as functional fibers. ACS Appl. Mater. Interfaces 2019, 11, 5462–5475. [Google Scholar] [CrossRef]
- Bhuyan, C.; Konwar, A.; Bora, P.; Rajguru, P.; Hazarika, S. Cellulose nanofiber-poly(ethylene terephthalate) nanocomposite membrane from waste materials for treatment of petroleum industry wastewater. J. Hazard. Mater. 2023, 442, 129955. [Google Scholar] [CrossRef]
- Cui, Y.; Liu, Y.; Gu, D.; Zhu, H.; Wang, M.; Dong, M.; Guo, Y.; Sun, H.; Hao, J.; Hao, X. Three-Dimensional Cross-Linking Network Coating for the Flame Retardant of Bio-Based Polyamide 56 Fabric by Weak Bonds. Reac. Funct. Polym. 2024, 16, 1044. [Google Scholar] [CrossRef] [PubMed]
- Luo, K.; Liu, J.; Abbay, K.; Mei, Y.; Guo, X.; Song, Y.; You, Q.G.Z. The Relationships between the Structure and Properties of PA56 and PA66 and Their Fibers. Polymers 2023, 15, 2877. [Google Scholar] [CrossRef]
- Kang, H.L.; Wang, Z.; Lin, N.; Hao, X.M.; Liu, R.G. Influence of drawing and annealing on the structure and properties of bio-based polyamide 56 fibers. J. Appl. Polym. Sci. 2022, 139, e53221. [Google Scholar] [CrossRef]
- Wang, A.; Zhou, X.; Li, D.; Li, H.; Liu, Q.; Deng, B.; Xu, W. Structure and properties of bio-based poly(trimethylene terephthalate)/polyamide 56 blends prepared by melt mixing. J. Appl. Polym. Sci. 2024, 141, e54797. [Google Scholar] [CrossRef]
- Eltahir, Y.A.; Saeed, H.A.M.; Xia, Y.M.; Yong, H.; Wang, Y.M. Mechanical properties, moisture absorption, and dyeability of polyamide 5,6 fibers. J. Text. I. 2015, 107, 208–214. [Google Scholar] [CrossRef]
- Morales-Gámez, L.; Soto, D.; Franco, L.; Puiggalí, J. Brill transition and melt crystallization of nylon 56: An odd–even polyamide with two hydrogen-bonding directions. Polymer 2010, 51, 5788–5798. [Google Scholar] [CrossRef]
- Kim, Y.H.; Hong, K.J.; Kim, H.; Nam, J.H. Influenza vaccines: Past, present, and future. Rev. Med. Virol. 2021, 32, e2243. [Google Scholar] [CrossRef] [PubMed]
- Kono, H.; Sogame, Y.; Purevdorj, U.; Ogata, M.; Tajima, K. Bacterial Cellulose Nanofibers Modified with Quaternary Ammonium Salts for Antimicrobial Applications. ACS Appl. Nano Mater. 2023, 6, 4854–4863. [Google Scholar] [CrossRef]
- Edgar, K.J.; Zhang, H. Antibacterial modification of Lyocell fiber: A review. Carbohyd. Polym. 2020, 250, 116932. [Google Scholar] [CrossRef] [PubMed]
- Campos, C.A.; Gerschenson, L.N.; Flores, S.K. Development of Edible Films and Coatings with Antimicrobial Activity. Food Bioprocess Tech. 2011, 4, 849–875. [Google Scholar] [CrossRef]
- Bian, N.; Yang, X.; Zhang, X.; Zhang, F.; Pei, J. A complex of oxidised chitosan and silver ions grafted to cotton fibres with bacteriostatic properties. Carbohyd. Polym. 2021, 262, 117714. [Google Scholar] [CrossRef]
- Yue, C.; Hu, M.; Zhang, R.; Qin, X.; Cheng, B. Microfluidic wet spinning of antibacterial collagen composite fibers supported by chelate effect of tannic acid with silver ions. React. Funct. polym. 2024, 194, 105798. [Google Scholar] [CrossRef]
- Pinho, A.C.; Piedade, A.P. Polymeric Coatings with Antimicrobial Activity: A Short Review. Polymers 2020, 12, 2469. [Google Scholar] [CrossRef]
- Berti, S.; Jagus, R.J.; Flores, S.K. Effect of Rice Bran Addition on Physical Properties of Antimicrobial Biocomposite Films Based on Starch. Food Bioprocess Tech. 2021, 14, 1700–1711. [Google Scholar] [CrossRef]
- Xiong, Y.S.; Wang, L.Y.; Xu, W.L.; Li, L.Y.; Tang, Y.H.; Shi, C.; Li, X.; Niu, Y.; Sun, C.; Ren, C. Electrostatic induced peptide hydrogel containing PHMB for sustained antibacterial activity. J. Drug Deliv. Sci. Tec. 2022, 75, 103717. [Google Scholar] [CrossRef]
- Peng, J.M.; Liu, P.M.; Peng, W.; Sun, J.; Shen, J. Poly(hexamethylene biguanide) (PHMB) as high-efficiency antibacterial coating for titanium substrates. J. Hazard. Mater. 2021, 411, 125110. [Google Scholar] [CrossRef]
- Huang, H.B.; Mao, L.; Wang, W.; Li, Z.H.; Qin, C.R. A facile strategy to fabricate antibacterial hydrophobic, high-barrier, cellulose papersheets for food packaging. Int. J. of Biol. Macromol. 2023, 236, 123630. [Google Scholar] [CrossRef] [PubMed]
- Rao, Y.; Wang, J.H.; Wang, H.H.; Wang, H.; Gu, R.; Shen, J.; Hao, Q.; Brash, J.L.; Chen, H. Optimizing the Bacteriostatic and Cytocompatibility Properties of Poly(hexamethylene guanidine) Hydrochloride (PHMG). Biomacromolecules 2022, 23, 2170–2183. [Google Scholar] [CrossRef] [PubMed]
- Jiang, Y.C.; Zheng, A.N.; Guan, Y.; Wei, D.F.; Xu, X.; Gong, W.L. Gene reconstruction spandex with intrinsic antimicrobial activity. Chem. Eng. J. 2021, 404, 125152. [Google Scholar]
- Wang, L.L.; Wang, X.; Du, Y.L.; Xu, X.; Bai, M.; Guan, Y.; Liu, X.C. Synthesis of a Low Metal-Corrosive and High-Antibacterial Effective Guanidine Salt Oligomer via Ion Exchange. ACS Appl. Polym. Mater. 2024, 6, 4509–4515. [Google Scholar] [CrossRef]
- Ge, F.; Wang, L.; Dou, Y.; Wei, J.; Cheng, L.; Wang, X.; Cui, Z.C. Elucidating the passivation kinetics and surface film chemistry of 254SMO stainless steel for chimney construction in simulated desulfurized flue gas condensates. Constr. Build. Mater. 2021, 285, 122905. [Google Scholar] [CrossRef]
- Zheng, C.; Liu, Z.; Chen, S.; Liu, C. Corrosion Behavior of a Ni–Cr–Mo Alloy Coating Fabricated by Laser Cladding in a Simulated Sulfuric Acid Dew Point Corrosion Environment. Coatings 2020, 10, 849. [Google Scholar] [CrossRef]
- Zhang, H.; Qian, S.; Zhu, R.; Yu, J.; Wang, X.; X, L. Preparation and properties of antibacterial biobase polyamide 56 and its fiber. Synthetic Fiber in China 2020, 49, 1–7. [Google Scholar]
- Zhu, C.; Lu, X.; Li, Y.; Deng, Y.; Lu, J.; Liu, Z.; Wu, H.; Tong, Y.; Qu, J. Enhancing Toughness of PLA/ZrP Nanocomposite through Reactive Melt-Mixing by Ethylene-Methyl Acrylate-Glycidyl Methacrylate Copolymer. Polymers 2022, 14, 3748. [Google Scholar] [CrossRef]
- Metwally, B.S.; Rashed, S.; El-Sheikh, M.; Hamouda, A. Dyeing of Recycled Electrospun Polyamide 6 Nanofibers: Implications of Dye Particle Size. Fiber. Polym. 2023, 24, 1681–1693. [Google Scholar] [CrossRef]
- Li, L.X.; Song, X.Y.; Fang, S.J.; Qian, L.; Qian, H.F. Urea-containing azo disperse dyes: Synthesis, application, and structure–property relationship for nylon fabrics. Dyes Pigm. 2022, 201, 110239. [Google Scholar] [CrossRef]
- Xue, C.; Hsu, K.M.; Chiu, C.Y.; Chang, Y.K.; Ng, I.S. Fabrication of bio-based polyamide 56 and antibacterial nanofiber membrane from cadaverine. Chemosphere 2020, 266, 128967. [Google Scholar] [CrossRef]
- Lin, H.A.; Ping, Q.J. Super-Toughened Poly(lactic Acid) with Poly(ε-caprolactone) and Ethylene-Methyl Acrylate-Glycidyl Methacrylate by Reactive Melt Blending. Polymers 2019, 11, 771. [Google Scholar] [CrossRef]
- Shentu, X.Y.; Guan, Y.; Wang, L.L.; Pan, J.; Zheng, A.N.; Wei, D.F.; Xu, X. Preparation of antibacterial down fibers by chemical grafting using novel guanidine salt oligomer. Polym. Advan. Technol. 2021, 32, 4082–4093. [Google Scholar] [CrossRef]
- Wu, H.; Hou, A.; Qu, J.P. Phase Morphology and Performance of Supertough PLA/EMA–GMA/ZrP Nanocomposites Prepared through Reactive Melt-Blending. ACS Omega 2019, 4, 19046–19053. [Google Scholar] [CrossRef]
- Martin, P.; Devaux, J.; Legras, R.; Gurp, M.V.; Duin, M.V. Competitive reactions during compatibilization of blends of polybutyleneterephthalate with epoxide-containing rubber. Polymer 2001, 42, 2463–2478. [Google Scholar] [CrossRef]
- Lin, W.Y.; Qu, J.P. Enhancing Impact Toughness of Renewable Poly(lactic acid)/Thermoplastic Polyurethane Blends via Constructing Cocontinuous-like Phase Morphology Assisted by Ethylene–Methyl Acrylate–Glycidyl Methacrylate Copolymer. Ind. Eng. Chem. Res. 2019, 58, 10894–10907. [Google Scholar] [CrossRef]
- Dong, W.Y.; Jiang, F.H.; Zhao, L.P.; You, J.C.; Cao, X.J.; Li, Y.J. PLLA microalloys versus PLLA nanoalloys: Preparation, morphologies, and properties. Acs Appl. Mater. Interfaces 2012, 4, 3667–3675. [Google Scholar] [CrossRef]
- Feng, Y.L.; Zhao, G.Y.; Yin, J.H.; Jiang, W. Reactive compatibilization of high-impact poly(lactic acid)/ethylene copolymer blends catalyzed by N,N-dimethylstearylamine. Polym. Int. 2014, 63, 1263–1269. [Google Scholar] [CrossRef]
- Chong, Y.; Zhuang, X.; Guan, C.; Wang, L.; Zheng, R.; Bie, Z. Preparation and performance study of POE-g-MAH/GMA toughened bio-based PA56 alloys. J. Alloy. Compd. 2023, 960, 170813. [Google Scholar] [CrossRef]
- Qiu, G.X.; Liu, G.Y.; Qiu, W.; Liu, S.S. Phase Morphology and Mechanical Properties of Polyamide-6/Polyolefin Elastomer-g-Maleic Anhydride Blends. J. Macromol. Sci. B 2014, 53, 615–624. [Google Scholar] [CrossRef]
- Wang, L.L.; Jiang, H.H.; Du, Y.L.; Zhao, Y.B.; Guan, Y.; Liu, X.C. Washable antibacterial modified bio-based PA56 with high toughness. ACS Appl. Polym. Mater. 2023, 5, 4986–4992. [Google Scholar] [CrossRef]
- Wang, X.D.; Feng, W.; Li, H.Q.; Jin, R.G. Compatibilization and toughening of poly(2,6-dimethyl-1,4-phenylene oxide)/polyamide 6 alloy with poly(ethylene 1-octene): Mechanical properties, morphology, and rheology. J. Appl. Polym. Sci. 2003, 88, 3110–3116. [Google Scholar] [CrossRef]
- Iqbal, K.; Javid, A.; Rehman, A.; Rehman, A.; Ashraf, M.; Abid, H.A. Single bath dyeing of modified nylon/cotton blended fabrics using direct/acid dyes. Pigm. Resin Technol. 2020, 49, 165–170. [Google Scholar] [CrossRef]
- Atherton, E.; Peters, R.H. Studies of the Dyeing of Nylon with Acid Dyes: Part II: Kinetics of the Process. Text. Res. J. 1956, 26, 497–517. [Google Scholar] [CrossRef]
- Simoni, B.; Kovac, F. A study of dye–surfactant interactions. Part 2. The effect of purity of a commercial cationic azo dye on dye–surfactant complex formation. Dyes Pigments 1999, 40, 1–9. [Google Scholar] [CrossRef]
- Rozamliana, J.; Gurung, J.; Pulikkal, A.K. Exploring the interactions of anionic dye tartrazine with cationic surfactants in aqueous solution: Insights into micellization and interfacial properties. Inorg. Chem. Commun. 2024, 159, 111740. [Google Scholar] [CrossRef]
- Tajima, J. The static electrification of nylon fabrics dyed with anthraquinone disperse dyes. Sen’i Gakkaishi 1970, 26, 426–431. [Google Scholar] [CrossRef][Green Version]
- Wang, W.Y.; Kan, C.W. An eco-friendly dyeing method: Bromophenol blue (BPB) applied for dyeing cotton fabrics coated with cationic finishing agents. Cellulose 2020, 27, 9045–9059. [Google Scholar] [CrossRef]
- Kawabata, A.; Taylor, J.A. The effect of reactive dyes upon the uptake and antibacterial efficacy of poly(hexamethylene biguanide) on cotton. Part 3: Reduction in the antibacterial efficacy of poly(hexamethylene biguanide) on cotton, dyed with bis(monochlorotriazinyl) reactive dyes. Carbohyd. Polym. 2007, 67, 375–389. [Google Scholar] [CrossRef]
- Kawabata, A.; Taylor, J.A. The effect of reactive dyes upon the uptake and anti bacterial action of poly(hexamethylene biguanide) on cotton. Part 2: Uptake of poly(hexamethylene biguanide) on cotton dyed with β-sulphatoethylsulphonyl reactive dyes. Dyes Pigm. 2006, 68, 197–204. [Google Scholar]

| Sample Name | PPGS Content (wt%) | EMA Content (wt%) | Bio-Based PA56 Content (wt%) |
|---|---|---|---|
| PA56 | 0.0 | 0.0 | 100.0 |
| GS-0.5 | 0.5 | 0.0 | 99.5 |
| GS-1.0 | 1.0 | 0.0 | 99.0 |
| GS-1.5 | 1.5 | 0.0 | 98.5 |
| GS-2.0 | 2.0 | 0.0 | 98.0 |
| GS-10.0* | 5.0 | 0.0 | 95.0 |
| GSE-0.5 | 0.5 | 0.5 | 99.0 |
| GSE-1.0 | 1.0 | 1.0 | 98.0 |
| GSE-1.5 | 1.5 | 1.5 | 97.0 |
| GSE-2.0 | 2.0 | 2.0 | 96.0 |
| GSE-10.0 * | 5.0 | 5.0 | 90.0 |
| Sample | T5% (°C) | Tmax (°C) |
|---|---|---|
| PPGS | 310.8 | 328.3 |
| PA56 | 381.5 | 432.4 |
| GS-0.5 | 368.5 | 438.2 |
| GS-1.0 | 363.9 | 443.0 |
| GS-1.5 | 359.2 | 443.1 |
| GS-2.0 | 347.6 | 438.1 |
| GSE-0.5 | 373.6 | 438.3 |
| GSE-1.0 | 370.9 | 443.1 |
| GSE-1.5 | 367.4 | 440.9 |
| GSE-2.0 | 363.2 | 438.6 |
| Samples | Elongation at Break (%) | Breaking Strength (cN/dtex) | Elastic Modulus (cN/dtex) |
|---|---|---|---|
| PA56 | 27.27 ± 0.94 | 4.11 ± 0.33 | 38.11 ± 2.65 |
| GS-0.5 | 26.08 ± 0.21 | 3.91 ± 0.37 | 32.28 ± 1.63 |
| GS-1.0 | 22.51 ± 1.97 | 3.83 ± 0.42 | 31.05 ± 1.73 |
| GS-1.5 | 20.24 ± 1.17 | 3.27 ± 0.22 | 25.67 ± 0.85 |
| GS-2.0 | 17.01 ± 1.28 | 2.89 ± 0.44 | 20.65 ± 1.23 |
| GSE-0.5 | 27.75 ± 1.45 | 3.93 ± 0.35 | 33.69 ± 1.37 |
| GSE-1.0 | 28.29 ± 1.57 | 3.86 ± 0.33 | 32.86 ± 0.56 |
| GSE-1.5 | 30.85 ± 1.20 | 3.62 ± 0.17 | 26.56 ± 0.72 |
| GSE-2.0 | 34.85 ± 1.29 | 3.34 ± 0.42 | 24.44 ± 1.36 |
| Samples | Before Dyeing | After Dye-Free Processing | After Acid Blue 80 Dyeing | After Neutral Grey 2BL Dyeing | After Disperse Blue 2BLN Dyeing |
|---|---|---|---|---|---|
| GS-0.5 | >99.99 | 55.43 | 28.50 | 53.25 | 25.36 |
| GS-1.0 | >99.99 | 58.70 | 39.12 | 55.82 | 22.43 |
| GS-1.5 | >99.99 | 88.04 | 45.58 | 85.64 | 20.68 |
| GS-2.0 | >99.99 | 97.83 | 59.19 | 95.23 | 34.24 |
| GSE-0.5 | 73.62 | 69.56 | 56.02 | 68.53 | 27.92 |
| GSE-1.0 | >99.99 | >99.99 | 82.57 | >99.99 | 28.71 |
| GSE-1.5 | >99.99 | >99.99 | 85.31 | >99.99 | 36.14 |
| GSE-2.0 | >99.99 | >99.99 | 87.90 | >99.99 | 57.77 |
Disclaimer/Publisher’s Note: The statements, opinions and data contained in all publications are solely those of the individual author(s) and contributor(s) and not of MDPI and/or the editor(s). MDPI and/or the editor(s) disclaim responsibility for any injury to people or property resulting from any ideas, methods, instructions or products referred to in the content. |
© 2024 by the authors. Licensee MDPI, Basel, Switzerland. This article is an open access article distributed under the terms and conditions of the Creative Commons Attribution (CC BY) license (https://creativecommons.org/licenses/by/4.0/).
Share and Cite
Wang, L.; Zhou, B.; Du, Y.; Bai, M.; Xu, X.; Guan, Y.; Liu, X. Guanidine Derivatives Leverage the Antibacterial Performance of Bio-Based Polyamide PA56 Fibres. Polymers 2024, 16, 2707. https://doi.org/10.3390/polym16192707
Wang L, Zhou B, Du Y, Bai M, Xu X, Guan Y, Liu X. Guanidine Derivatives Leverage the Antibacterial Performance of Bio-Based Polyamide PA56 Fibres. Polymers. 2024; 16(19):2707. https://doi.org/10.3390/polym16192707
Chicago/Turabian StyleWang, Lili, Bobo Zhou, Yuliu Du, Miao Bai, Xiang Xu, Yong Guan, and Xiucai Liu. 2024. "Guanidine Derivatives Leverage the Antibacterial Performance of Bio-Based Polyamide PA56 Fibres" Polymers 16, no. 19: 2707. https://doi.org/10.3390/polym16192707
APA StyleWang, L., Zhou, B., Du, Y., Bai, M., Xu, X., Guan, Y., & Liu, X. (2024). Guanidine Derivatives Leverage the Antibacterial Performance of Bio-Based Polyamide PA56 Fibres. Polymers, 16(19), 2707. https://doi.org/10.3390/polym16192707
